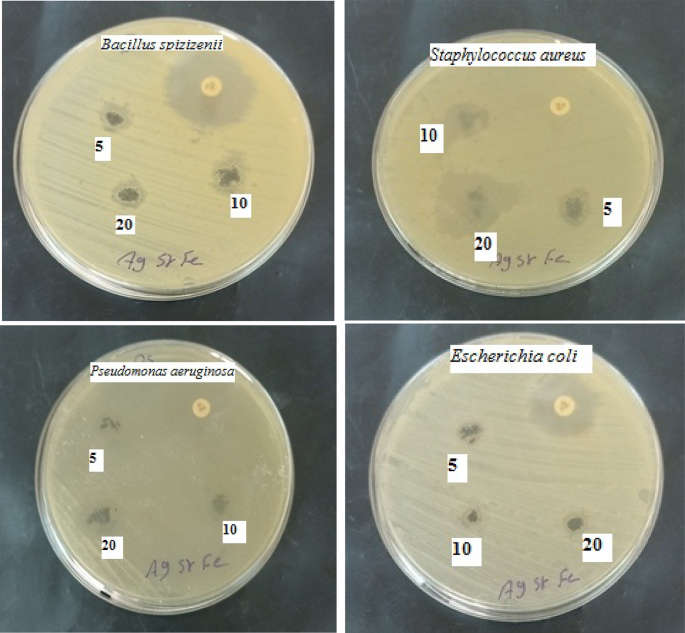
Fig. 14

Abstract
In this study, Ag/Sr0.85Ag0.15FeO3−δ composite was prepared by sol-gel method. The structure, morphology, and surface properties of this composite have been characterized by X-ray diffraction (XRD) combined with Rietveld analysis, transmission electron microscopy (TEM), X-ray photoelectron spectroscopy (XPS), and Mössbauer spectroscopy. XRD and TEM results confirm the existence of the perovskite phase of Sr0.85Ag0.15FeO3−δ and Ag nanoparticles. XPS and Mössbauer spectroscopy results indicate the existence of oxygen vacancies (δ) and different oxidation states of Fe ions. The band gap energy (Eg) of this composite is 3.53 eV and lies in the UV region. The magnetic hysteresis loop (M-H) of this composite reveals the existence of an exchange bias effect because of the competition between antiferromagnetic (AFM) and ferromagnetic order (FM). Electrochemical measurements indicated that the Ag/Sr0.85Ag0.15FeO3−δ composite exhibits pseudocapacitive behavior. The present composite showed strong antimicrobial activity to fight both tested Gram-positive and Gram-negative bacteria as well as unicellular and filamentous fungi strains.
Similar content being viewed by others
Introduction
Recently, Ag doped SrFeO3−δ perovskites have attracted attention because of its excellent electronic, optical, magnetic, electrochemical, antibacterial properties which due to the existence of Ag+, oxygen vacancies (δ), and mixed valence states of Fe ions1,2,3. Consequently, they have various applications such as fuel cells, catalysts, electrochemical sensors, supercapacitors, and antibacterial agents for the types of bacteria that resist the antibiotic4,5. The crystal structure of SrFeO3−δ perovskite depends on the concentration of oxygen vacancies values (δ)4,6. Therefore, below δ = 0.25, the SrFeO3−δ perovskite was crystallized in an orthorhombic structure which is composed of Fe4+O5 square pyramidal and Fe3+O6 distorted octahedra4,6. The valence states, spin state, and the coordination of Fe as well as oxygen vacancies content in SrFeO3−δ perovskite can be determined by the Mössbauer spectroscopy technique7,8. Abd El-Naser et al.8 have analyzed the Mössbauer spectrum of SrFeO3−δ perovskite and they found that there is a magnetic sextet, two quadrupole doublets, and a single line. They also found that the oxygen vacancies content is 0.135. Rosa et al.2 investigated the magnetic and electronic properties of Ag-doped SrFeO3 perovskite using quantum simulations and demonstrated that Ag-doping leads to the modification of the magnetic order through the change in the concentration of oxygen vacancies (δ). Williams et al.4 investigated the magnetic properties of Sr4Fe4O11 orthorhombic phase and they found that Sr4Fe4O11 orthorhombic exhibits an exchange bias effect near Néel temperature (TN ~230 K).
In modern experiments, SrFeO3−δ perovskite and its derivatives have been investigated as a promising electrode material for energy storage applications9,10. Further, Ag-doped perovskite oxides lead to the improvement of specific capacitance and cyclic stability because of Ag-comprising electrode has high activity in the reaction of oxygen reduction11,12. Lang et al.12 studied the Ag nanoparticles decorated La0.85Sr0.15MnO3 as electrode materials of supercapacitors and demonstrated that their presence leads to the acceleration of charge transfer and contributes in pseudocapacitance with a small amount. Ahangari et al.9 studied the SrFeO3 and SrCo0.5Fe0.5O3 perovskites as electrode materials of supercapacitors and found that the partial substitution of Fe by Co leads to the reduction in the specific capacitance.
Ag nanoparticles in nanocomposite are safe potent antibacterial agent and nontoxic as well as they are used for killing much types of bacteria that cause diseases5,13. Abdel-Khalek et al.3,7 studied the antibacterial activities of Ag-doped SrFeO3−δ perovskite. They found that the addition of a low concentration of Ag (0.05 and 0.10) leads to the enhancement of its antibacterial activity owing to inherent bacteria resistance for Ag nanoparticles. Duran et al.13 compared the antibacterial activities between the silver ions (Ag+) and silver nanoparticles. They found that the Ag+ ions lead to inactivation of bacteria because they react with proteins in the thiol groups14. Li et al.15 discussed the antibacterial activities mechanism of silver nanoparticles through three possible mechanisms. First, silver nanoparticles can be directly attached to the cell membrane and consequently damage it. Second, silver nanoparticles can be penetrated inside the bacteria and consequently lead to DNA damage13. Third, silver nanoparticles can generate the reactive oxygen species and consequently lead to the death of bacteria16.
In view of the aforementioned aspects, the significant problem of SrFeO3−δ perovskite as an electrode material is its low performance and the unstability of its structure11,17. In order to solve this problem, we fabricate the Ag/Sr0.85Ag0.15FeO3−δ composite by sol-gel method. This composite contains mixed electronic (Fe3+/Fe4+) and ionic (Ag) conductors which are able to transfer both ions and electrons at the same time. In addition, we expect the presence of both the silver ions (Ag+) and silver nanoparticles in the Ag/Sr0.85Ag0.15FeO3−δ composite which enhancement the antibacterial activity of this composite. Therefore, the aim of the present work is the improvement of the electrochemical and antibacterial properties of Ag/Sr0.85Ag0.15FeO3−δ composite as electrode materials and antibacterial agent.
Experimental
Sample preparation
Ag/Sr0.85Ag0.15FeO3-δ composite was prepared by sol-gel method using citric acid (C6H8O7) as a complexing agent. The grade chemicals Sr(NO3)2 (99%) and Fe(NO2)3·9H2O (98%) were obtained from Loba Chemie while Ag(NO3)2 (99%), citric acid C6H8O7 (99.8%) and ethylene glycol C2H6O2 (99.5%) were obtained from Alpha Chemika. The experimental details about the preparation method of this composite were reported in a previous work3. The experimental flowchart of the sol-gel method for the preparation of Ag/Sr0.85Ag0.15FeO3-δ composite is shown in Fig. 1.
Flowchart of the sol-gel method for the synthesis of the Ag/Sr0.85Ag0.15FeO3−δ composite.
Characterization
X-ray diffraction (XRD) pattern of this composite at room temperature was carried out by a Bruker Co D8 Discover X-ray diffractometer with a Cu Kα radiation source (λ = 1.5406 Å) in the 2θ range of 10° − 80° and scanning rate of 0.02°. Rietveld analysis of XRD data of this composite was performed by Fullprof suite. The transmission electron microscopy (TEM) image and selected area electron diffraction (SAED) pattern were obtained using a JEM-2100 PLUS (Japan) electron microscope. The used accelerating voltage is 200 kV. The energy dispersive X-ray spectroscopy (EDS) elemental mapping of this composite was determined using a JEM-2100 F (URP) instrument. X-ray photoelectron spectroscopy (XPS) measurement of this composite was performed by K-Alpha™ photoelectron spectrometer (Thermo Scientific™ (USA)) using a monochromatic AL-Kα radiation source. The Mössbauer spectrum of this composite was measured by a conventional constant acceleration spectrometer with 57Co (embedded in a Cr matrix) radioactive source at room temperature. The absorption spectrum of this composite was carried out using UV-Vis. spectrophotometer (Jasco-V-570) in the wavelength range from 200 to 800 nm. The room temperature magnetization hysteresis (M-H) loop of this composite was performed by vibrating the sample magnetometer (VSM of Lake Shore 7410).
Electrochemical properties study
The electrochemical properties of the composite were performed in a 6 M KOH aqueous electrolyte using a potentiostat-galvanostat unit (OrigaFlex, France). The electrochemical measurements were studied in three electrode cells using a nickel foam coated with the present composite as a working electrode, platinum (Pt) plate as the counter electrode, and Hg/HgO as the reference electrode. The cyclic voltammetry (CV) measurements of this composite were performed within a potential window of 0 to 0.5 V at different scanning rates (5, 10, 25, 50, and 100 mV/s). The galvanostatic charge/discharge (GCD) measurements of this composite were performed at different current densities (1, 2, 3, 4, and 5 A/g) over a potential window of 0 to 0.5 V. The electrochemical impedance spectroscopy (EIS) measurement of this composite was performed over the frequency range of 100 kHz to 100 MHz using Nyquist plot. The specific capacity (C) of this composite was estimated through the GCD curves by the following Eq.
where I is the discharging current (A), dt represents the discharge time, and m is the mass of active material (g) within the electrode. Further, the specific capacitance (Cs) of this composite was estimated through the GCD curves by the following relation.
where ∫Vdt represents the area under the discharge of the GCD curve, and ΔV is the discharging potential range (V).
Antibacterial properties study
The antimicrobial activity in vitro of the Ag/Sr0.85Ag0.15FeO3−δ composite in different concentrations against a wide range of pathogens was studied using the agar disc diffusion method3. Gram-positive (Bacillus spizizenii (ATCC 6633) and Staphylococcus aureus (ATCC 6538)) and Gram-negative (Pseudomonas aeruginosa (ATCC 9027) and Escherichia coli (ATCC 8739)) bacteria were studied against the investigated composite. Further, unicellular (Candida albicans (ATCC 10231)) and filamentous (Aspergillus brasiliensis (ATCC 16404)) fungi were studied against the investigated composite. Standard antibacterial and antifungal agents were Imipenem (IPM 10) and Fungzol, respectively. In accordance CLSI guidelines18, the inhibition zones diameters were determined after 24 h of incubation for bacteria and 3 days for fungi at 37 °C.
Results and discussion
XRD, TEM, SAED, and HRTEM studies
Figure 2 displays the Rietveld refined XRD pattern of the Ag/Sr0.85Ag0.15FeO3−δ composite. This pattern showed the coexistence of orthorhombic (space group Pnma) and cubic (space group Fm3m) phases for Sr0.85Ag0.15FeO3−δ perovskite and Ag metallic, respectively19,20,21,22. The Rietveld refinement parameters of this composite such as the phase fraction, lattice parameters, unit cell volume, atoms, Wyckoff position, lattice coordinate, and reliability R-factors (RB and RF) are tabulated in Table 1. From this table, it is noticed that the crystal structure of the present composite consists of dominant orthorhombic phase (81.53%) for Sr0.85Ag0.15FeO3−δ perovskite with a minor cubic phase (18.47%) for Ag metallic. By comparing the obtained XRD result with the previous results for Sr1 − xAgxFeO3−δ (where x = 0.05 and 0.10) perovskite, the transition from cubic (Pm-3 m) to orthorhombic structure (Pnma) was occurred with increasing Sr content to x = 0.153. This transition can be attributed to the presence of high amount of oxygen vacancies as confirmed by the following XPS and Mössbauer results23. The crystallite size (D) of Sr0.85Ag0.15FeO3−δ perovskite has been estimated by the following Williamson-Hall model24.
Rietveld refinement XRD patterns of the present composite and the diffraction peaks with stars are attributed to the metallic Ag as well as the inset displays the plot of βcosθ against 4sinθ for Sr0.85Ag0.15FeO3−δ perovskite.
where β is the difference in full-width at half maximum (FWHM) between the observed broadening (βobs) of the XRD peaks of perovskite in radiant and the instrumental broadening (βstd)25. The βstd value was estimated from the XRD pattern of standard Corundum Al2O3 sample. Additionally, ε is the microstrain, θ is the diffraction angle of the peaks, k = 0.9 is the constant, and λ = 0.15406 nm is the wavelength of the X-ray radiation source. The inset of Fig. 2 displays the plot of βcosθ against 4sinθ for Sr0.85Ag0.15FeO3−δ perovskite. The D value of the Sr0.85Ag0.15FeO3−δ perovskite can be estimated from the y-intercept (kλ/D) of the fitted line and it is equal to 37.47 nm26.
Figure 3a and b displays the TEM image of the Ag/Sr0.85Ag0.15FeO3-δ composite and the particle size distribution histogram of Ag particles, respectively. The image revealed the presence of aggregated sheets of the Sr0.85Ag0.15FeO3-δ perovskite and contains small spherical particles of Ag1,3. This observation provides evidence for the presence of Sr0.85Ag0.15FeO3-δ perovskite and metallic Ag in the present composite, which is in agreement with the above XRD results. The aggregation of the Sr0.85Ag0.15-xFeO3-δ perovskite in this composite can be attributed to their magnetic properties, in agreement with the following magnetic results27. The histogram of Ag particles, fitted using a Gaussian function, exhibits a narrow particle size distribution as shown in Fig. 3b which indicates the particle size distribution is uniformed. The estimated average particle size of Ag from the histogram is 7.72 nm. Figure 4a and b displays the HRTEM image and SAED pattern of the Ag/Sr0.85Ag0.15FeO3-δ composite, respectively. The HRTEM image exhibits two types of lattice fringes which can be attributed to Sr0.85Ag0.15FeO3-δ perovskite and Ag nanoparticle, proving the presence of them in this composite3. This result is in agreement with previous result for Ag/SrFeO3 composite1. The observed interplanar distance values of 0.27 and 0.23 nm indexes to the d spacings of the (1 2 1) and (1 1 1) crystal planes of the orthorhombic phase of Sr0.85Ag0.15FeO3-δ perovskite and the cubic phase of metallic Ag, respectively1. This finding agrees with the d-values which obtained from the XRD analysis for the Sr0.85Ag0.15FeO3-δ perovskite and matched with the JCPDS no. 87–0718 for Ag21. From Fig. 4b, SAED pattern exhibits diffraction rings with relatively sharp spots which indicate the polycrystalline nature of this composite7,8. The planes of (1 2 1), (1 2 3), (3 2 3) and (4 2 0) are assigned to orthorhombic structure of Sr0.85Ag0.15FeO3-δ perovskite while the others planes of (111) and (220) planes are assigned to a cubic structure of metallic Ag28. This result is in agreement with the previous result for Ag/SrFeO3 composite1. Figure 5 displays the EDS mapping images of the Ag/Sr0.85Ag0.15FeO3-δ composite. The EDS mapping images indicate the existence of Sr (yellow), Ag (green), Fe (red), and O (blue) elements without any impurities. Moreover, the distribution of Ag element in metallic Ag was observed in different regions while the distribution of Ag, Sr, Fe, and O elements in Sr0.85Ag0.15FeO3-δ perovskite are uniform, consistent with the XRD and TEM analysis.
a and b The transmission electron microscopy image of present composite and the particle size distribution histogram of Ag+ particles, respectively.
a and b The high-resolution TEM (HR-TEM) image of the present composite and the selected area electron diffraction (SAED) pattern, respectively.
The energy dispersive X-ray spectroscopy (EDS) mapping images of the present composite.
XPS and Mössbauer studies
Figure 6a, b, c, and d displays the deconvoluted XPS spectra of Ag 3d, Sr 3d, Fe 2p, and O 1s regions of the composite, respectively. It is notice that the XPS spectra in this composite indicated the existence of Ag, Sr, Fe, and O elements without any impurities, in agreement with the EDS mapping results. According to Fig. 6a, the XPS spectrum of the Ag 3d was deconvoluted into four peaks at 368.6, 370.76, 374.17, and 376.81 eV29,30. The double peaks at 368.6 and 374.17 eV are assigned to the metallic Ag 3d5/2 and Ag 3d3/2 states, respectively30,31. These peaks can be attributed to the reduction of Ag in AgNO3 during sol-gel process; thus, some Ag species exist on the surface of the perovskite sheets29,32. Additionally, the double peaks at 370.76 and 376.81 eV are assigned to the Ag1+ 3d5/2 and Ag1+ 3d3/2 states, which can be attributed to the oxidation of some Ag species to Ag2O after sintering in air29. According to Fig. 6b, the XPS spectrum of Sr 3d was deconvoluted into three peaks at 133.77, 136.36, and 138.73 eV. The peak at 136.36 eV is assigned to the 3d3/2 of Sr2+ ions into the perovskite structure7,27. The two peaks at 133.77 and 138.73 could be ascribed to 3d5/2 of Sr2+ ions accompanied with oxygen vacancies27,33. According to Fig. 6c, the XPS spectrum of Fe 2p was deconvoluted into six peaks of 2p3/2 and 2p1/2 electron levels and a weak satellite peak. These peaks are at 711.29, 714, 717.44, 721.4, 725.38, 728.72, and 732.34 eV. The double peaks at 711.29 and 725.38 eV are assigned to 2p3/2 and 2p1/2 states of Fe3+, respectively29,34. Further, the double peaks at 714 and 728.72 eV are due to 2p3/2 and 2p1/2 states of Fe4+ ions, respectively2. The satellite peak at 717.44 eV could be ascribed to 2p3/2 of Fe3+ accompanied by oxygen vacancies7,29. The additional sub-peak at 721.4 eV could be ascribed to 2p1/2 of Fe3+ ions while the peak at 732.34 eV is due to Fe 2p1/2 and can be attributed to the satellite structure7,29. From the above observation, it can be concluded that the presence of mixed oxidation states of Fe ions (3 + and 4+). According to Fig. 6d, the XPS spectrum of O 1s was deconvoluted into two peaks at 531.72 and 534.17 eV. This result showed that there are two kinds of oxygen states at the surface of this composite8,29. The peak at 531.72 eV is corresponding to the lattice oxygen (Olatt) which is due to the contribution of Ag-O, Sr-O, and Fe-O in the crystal lattice29,30. In addition, the peak at 534.17 eV is assigned to the surface adsorbed oxygen (Oads) which resulted from oxygen vacancies8,35. The percentages of Olatt and Oads are 42.39 and 57.61, respectively, which can be obtained from the fitting of XPS spectrum as shown in Fig. 6d. Therefore, the ratio of Oads/Olatt is 1.36 which means that the present composite has a high content of oxygen vacancy17.
a, b, c, and d Deconvoluted XPS spectra of Ag 3d, Sr 3d, Fe 2p, and O 1s of the present composite, respectively.
Figure 7 displays the Mössbauer spectrum at room-temperature for the present composite. It is noticed that this spectrum is composed of magnetic sextet, single line, and doublet. The appearance of magnetic sextet in this spectrum indicated the existence of magnetic order of AFM while the appearance of paramagnetic doublet indicated the existence of small amount ferromagnetic particles (superparamagnetic)36,37,38,39. This observation is supported by the following magnetic results and agreement with the previous report for SrFeO3−δ ceramic8. Further, the single line and paramagnetic doublet in this spectrum indicate presence of Fe in two different valence states7,8. The Mössbauer parameters such as isomer shift (IS), quadrupole splitting/quadrupole shift (QS/ε), magnetic field (B), and the relative area (A) are listed in Table 2. The magnetic sextet has a value of IS = 0.406 mms− 1 and a magnetic field of 39.7 T with small ε = -0.765 mms− 1 which is due to Fe3+ ions in the octahedral site40,41,42. The single line has a low value of IS = − 0.057 mms− 1 with QS = 0.261 mms− 1 which is due to Fe4+ ions in octahedral coordination38,42. The doublet has IS = 0.18 mms− 1 with QS = 0.548 mms− 1 which is due to Fe3+ ions in six coordinated octahedrons44. This observation indicates the existence of the orthorhombic phase that was detected by the above XRD result42. From Table 2, the QS value of Fe3+ is larger than that of Fe4+ which resulted from the presence of oxygen vacancies with Fe3+ ions43. Based on the charge balance between Fe4+ and Fe3+ ions, the oxygen vacancies parameter (δ) in this composite can be estimated by using the following relation7.
The Mössbauer spectrum of Ag/Sr0.85Ag0.15FeO3−δ composite recorded at room temperature.
where \({f_{F{e^{4+}}}}\) represent the fractions of Fe4+ ions in the sample. The δ value in this composite is 0.38, indicating the presence of orthorhombic phase of Sr0.85Ag0.15FeO3-δ perovskite.
Optical, magnetic, and electrochemical studies
Figure 8 displays the UV-Vis. absorption spectrum of the present composite. In the UV range, the spectrum exhibits absorption peak at 298 nm while in the Vis. range, the spectrum exhibits two board absorption peaks around 580 and 708 nm (as shown in the inset of Fig. 8). The absorption peak in the UV range may be due to the transfer of charge from O 2p level to 3eg orbital3,7. Additionally, the absorption peak in Vis range may be due to the transfer of charge from O 2p to Fe 3d accompanied with oxygen vacancies3,7. The band gap energy (Eg) of the present composite can be estimated from Wood and Tauc’s equation45.
The UV-Vis. absorption spectrum of the Ag/Sr0.85Ag0.15FeO3−δ composite in the wavelength range of 200–800 nm and the inset shows the magnified the Vis. range.
where α is the absorption coefficient, hν is the photon energy, C is a constant, and n is the exponent depends on the nature of the transition (n = ½ for a direct allowed transition)3. The absorption coefficient (α) can be calculated from Kubelka-Munk (K-M) function F(R) by the following Eqs.7,46.
where R is the diffuse reflectance. Figure 9 displays the plot of (F(R) hν)2 against hν for the present composite. The Eg value of the present composite can be estimated from the intersection of tangent line with (F(R) hν)2=0. The Eg value of this composite is 3.53 eV that lies in the UV region. This value indicates that the present composite has semiconductor properties27,47. Additionally, the small Eg value is due to the existence of oxygen vacancies close to the conduction band which cause the formation of extra energy levels45.
The plot of (F(R) hν)2 against hν of the Ag/Sr0.85Ag0.15FeO3−δ composite.
Figure 10 displays the room temperature M-H hysteresis loop of the present composite. This loop shows the presence of mainly AFM with small fraction of ferromagnetic order3,27. This finding is in agreement with above Mössbauer result and is similar to that reported by Abdel-Khalek et al. for Sr1-xAgxFeO3-δ (where x = 0.05 and 0.10) perovskite sample3. The AFM order in this composite may be due to the superexchange (SE) interaction of Fe3+−O − Fe3+ and Fe4+−O − Fe4+3,48. The small fraction of ferromagnetic (FM) order in this composite is due to the double exchange (DE) interaction between Fe4+−O − Fe3+3,49. The magnified of the central region of the M-H loop of this sample is shown in the inset of Fig. 10. It is noticed that the M-H loop is asymmetric and displays a shift in both the negative field and positive magnetization axes4,50. This observation shows the presence of an exchange bias phenomenon in the present composite which is similar to that reported by Williams et al. and Kumar et al. for SrFeOx and Ti doped SrFeO3-δ, respectively4,50. The exchange bias effect in this composite is due to the exchange coupling between the AFM ordered moments and FM-ordered spins at the interface between them4,50. The existence of the exchange bias phenomenon at room temperature in this composite makes it a promising material for magnetic applications4,48. The magnetic parameters, magnetization at maximum applied field (Ms), remanent magnetization (Mr), and coercive field (Hc) of this composite are 1.6100 emu/g, 0.58877 emu/g, and 1117.7 G, respectively. The smaller value of Mr can be attributed to the coexistence of FM within AFM26. The magnetic parameters for this composite are greater than that reported by Abdel-Khalek et al. for the Sr0.90Ag0.10FeO3-δ perovskite sample which may be due to the increase in oxygen vacancies as discussed earlier in XPS and Mössbauer results3. It is known that the value of the squareness parameter (k = Mr/Ms) indicates the type of interaction between nanoparticles. The k value for the present composite is 0.365 which indicates that the type of interaction between nanoparticles is magnetostatic51. Further, the large value of Hc in this composite indicates the transforms of the hysteresis loop from soft to hard3,51.
The M-H hysteresis loop of the Ag/Sr0.85Ag0.15FeO3−δ composite at room temperature.
Figure 11a displays the CV curves of the Ag/Sr0.85Ag0.15FeO3−δ electrode at different scan rates of 5, 10, 25, 50, and 100 mV/s. The CV curves exhibit redox peaks which indicate that the present electrode exhibits typical pseudocapacitive behavior1,9. The presence of redox peaks in the present electrode can be attributed to the Fe3+/Fe4+ and Ag/Ag2O redox reactions in the electrolyte9,12. The small redox peaks of Ag/Ag2O in this composite (as shown in inset Fig. 11a) are similar to that reported by Lang et al. and Lang et al. for Ag/La0.85Sr0.15MnO3 and Ag/La0.7Sr0.3CoO3−δ perovskite sample12,22. In addition, the presence of δ in the Ag/Sr0.85Ag0.15FeO3−δ composite leads to the enhancement of redox reactions where δ in the Ag/Sr0.85Ag0.15FeO3−δ electrode adsorbed the electrolyte ions26,52. The existence of Fe3+/Fe4+ and oxygen vacancies in this composite is confirmed by the above XPS and Mössbauer measurements. The Ag/Ag2O redox reactions can be attributed to the Ag particles which are confirmed by above XRD, TEM, and XPS measurements. Based on XPS spectra of Ag and Fe as well as Mössbauer spectrum, the conversion of Ag and Fe state in the Ag/Sr0.85Ag0.15FeO3−δ composite can be explained by the following chemical reactions12,22:
a and b The cyclic voltammetry (CV) curves of the Ag/Sr0.85Ag0.15FeO3−δ composite at different scanning rates of 5, 10, 25, 50, and 100 mVs− 1 and the plot of log (i) against log (ν) for the present composite, respectively.
where OH− represents the hydroxyl in the alkaline electrolyte (6 M KOH) and δ represents oxygen vacancies. The charge storage in these chemical reactions may be described through the generation of O2− and H2O during the charge which result from the absorption of OH−. Subsequently O2− diffuse to fill the oxygen vacancies sites and Fe3+ can be oxidized to Fe4+9. As the scan rate increases, it is noticed that the small redox peaks of Ag/Ag2O are weakening due to the insufficient reaction of electron neutralization12. The oxidation and reduction peaks of Fe were also shifted to higher potential and lower potential, respectively. This behavior can be due to the presence of fast electronic at a high scanning rate1. From the above observation, it can con be concluded that the presence of Ag nanoparticles in present composite leads to the acceleration of charge transfer and contributes in pseudocapacitance with a small amount12. To further clarify the electrochemical behaviors of the present composite, we use the power law relationship with the scan rate, as given in the following equation22.
where i is the anodic or cathodic peak current (mA), a and b are adjustable parameters, and ν is the scan rate (mV s− 1). Figure 11b displays the plot of log (i) against log (ν) for the present composite. The value of b of this composite can be obtained from the slope of the linear plot of log (i) against log (ν). The b values are 0.74 and 0.73 for anodic or cathodic peak, respectively. These values indicate the charge storage of this composite which was obtained from a mixture process involving capacitive and linear diffusion12,22.
Figure 12a displays the GCD curves of the Ag/Sr0.85Ag0.15FeO3−δ electrode at different current densities of 1, 2, 3, 4, and 5 A/g, respectively. It can be noted that these curves show a rapid potential drop on the left side and the potential decay on the right side. This observation confirmed the existence of pseudocapacitive behavior of the Ag/Sr0.85Ag0.15FeO3−δ electrode, which is in good agreement with redox peaks observed in CV curves22. Additionally, these curves exhibit discharge plateau at a high current density of 5 A/g. which indicates the good electrochemical performance of the present composite12. Figure 12b displays the plot of the specific capacity (C) and specific capacitance (Cs) of the Ag/Sr0.85Ag0.15FeO3−δ electrode as a function of current density. It is noticed that the C and Cs values of this composite decreases with increasing the current density which means the presence of good supercapacitors performance. This result can be due to the internal resistance consumption and increasing polarization effect24. Figure 13 shows the Nyquist plot obtained from the EIS data of the Ag/Sr0.85Ag0.15FeO3−δ electrode over the frequency range of 100 kHz to 100 MHz. It can be noted that the Nyquist plot displays a curved line at high frequency and nearly straight line at low frequency region. The Nyquist plot was analyzed by Zview™ software based on the equivalent circuit as shown in inset of Fig. 13. In the equivalent circuit, Rs is series resistance, CPE is the constant phase element, Rp is the charge transfer resistance and Wo is Warburg resistance53. The Nyquist fitting results such as RS, Rp, and Warburg diffusion resistance (W0) values of Ag/Sr0.85Ag0.15FeO3−δ electrode are equal to 0.40, 121.5 and 529 Ω, respectively, and the capacitance (CPET), the constant phase element exponent (CPEP), the diffusion time constant (WT) and a fractional exponent (Wp) are equal to 0.015, 0.787, 20.41, and 0.921 respectively. The smaller values of RS and Rp of the Ag/Sr0.85Ag0.15FeO3−δ electrode indicate the lower activation energy for the electron transfer reaction and the fast of the oxygen reduction reaction, respectively40. In addition, the smaller values of RS and Rp in the present composite are due to the high content of oxygen vacancies (δ) which increase the electrical conductivity and the dynamics of the charge transfer24. The existence of oxygen vacancy sites in the structure of this composite leads to the increase pathways for the diffusion of the electrolyte ions9. The high value of W0 indicates the less contact between the active material and Ni foam53.
a The galvanostatic charge-discharge (GCD) curves of the Ag/Sr0.85Ag0.15FeO3−δ composite at different current densities of 3, 4, and 5 A/g. b The specific capacity (C) and specific capacitance (Cs) of the present composite, respectively.
The Nyquist plot of the Ag/Sr0.85Ag0.15FeO3−δ composite and the inset shows the equivalent circuit of the Ag/Sr0.85Ag0.15FeO3−δ electrode.
Antibacterial properties of Ag/Sr0.85Ag0.15FeO3−δ composite
Figure 14 shows the antibacterial activity of Ag/Sr0.85Ag0.15FeO3−δ composite against Gram-positive (Bacillus spizizenii and Staphylococcus aureus) and Gram-negative (Pseudomonas aeruginosa and Escherichia coli) bacteria at concentrations of 5, 10, and 20 mg. The antibacterial activity screening method in the present composite is the inhibition zone. The inhibition zone diameters of the investigated composite against gram-positive and gram-negative bacteria as a function of concentrations are tabulated in Table 3. It is noted that the inhibition zone diameters for the gram positive and gram-negative bacteria increase with increasing the concentration of the composite sample from 5 to 20 mg. Staphylococcus aureus and Pseudomonas aeruginosa bacteria exhibited resistance to the current antibiotic (Imipenem) but the present composite exhibited antibacterial activity for these types of bacteria as shown in Fig. 14; Table 3. Moreover, the inhibition zone of gram-positive (Staphylococcus aureus) is larger than that of gram-negative bacteria (Escherichia coli) while the inhibition zone of gram-negative (Pseudomonas aeruginosa) is larger than that of gram-positive bacteria (Bacillus spizizenii) at all concentrations. This result can be attributed to the difference in both the morphology and the wall of the cells of the bacteria14,16. The damage and cell death of both gram positive and gram-negative bacteria could be due to the presence of small spherical particle size of Ag which can easily reach the nuclear content of the bacteria3,13. Additionally, the toxic effect of the present composite can be due to the presence of reactive oxygen species (ROS) and the liberation of Sr2+ ions which make the environment around the bacteria unhealthy3,16. Figure 15. shows the antifungal activity of Ag/Sr0.85Ag0.15FeO3−δ composite against unicellular (Candida albicans (ATCC 10231)) and filamentous fungi (Aspergillus brasiliensis (ATCC 16404)) at concentrations of 5, 10, and 20 mg. The inhibition zone diameters of the investigated composite against unicellular and filamentous fungi at different concentrations are tabulated in Table 3. It is noted that the diameter of the inhibition zone for Candida albicans fungi increases with increasing the concentration of the composite while Aspergillus terreus fungi exhibited antifungal activity at high concentration only (20 mg). This observation can be attributed to the small spherical particle size of Ag in the present composite which disrupts fungal physiology3,15.
The antimicrobial activity (Bacillus spizizenii, Staphylococcus aureus, Pseudomonas aeruginosa and Escherichia coli) of the Ag/Sr0.85Ag0.15FeO3−δ composite at concentrations of 5, 10, and 20 mg.
The antifungal activity of Ag/Sr0.85Ag0.15FeO3−δ composite (Candida albicans (ATCC 10231)) and Aspergillus brasiliensis (ATCC 16404)) at concentrations of 5, 10, and 20 mg.
Conclusion
Ag/Sr0.85Ag0.15FeO3−δ composite was prepared by the sol-gel method. From XRD, TEM and SAED analysis, we concluded that there are orthorhombic (space group Pnma) structure of Sr0.85Ag0.15FeO3−δ perovskite and cubic (space group Fm3m) structure of Ag metallic in this composite. The average particle size of Ag in this composite is 7.72 nm which was evaluated by TEM. According to XPS and Mössbauer spectral analysis, we concluded that there are oxygen vacancies (δ), Fe3+, and Fe4+ ions in this composite. Optical results of this composite revealed that the value of Eg is 3.53 eV and lies in the UV region. M-H hysteresis loop of this composite showed the exchange bias effect at room temperature. Electrochemical results indicated that the Ag/Sr0.85Ag0.15FeO3−δ composite can be a good candidate of electrode material for energy storage applications. The antibacterial tests of this composite showed strong activity to fight some types of gram-positive (Staphylococcus aureus (ATCC 6538)) and gram-negative (Pseudomonas aeruginosa (ATCC 9027)) bacteria that resist the current antibiotic (Imipenem). Finally, these findings indicate that this composite can be used as a promising material for magnetic, biomedical, and energy storage applications.
Data availability
All the data are available within this paper.
References
Kesavan, G., Subramaniam, T. & Manemaran, H. V. Development of promising Flower-like Ag/SrFeO3 nanosheet electrode materials: an efficient and selective electrocatalytic detection of caffeic acid in coffee and green tea. ACS Omega. 8, 46414–46424 (2023).
Rosa, G. B., Lacerda, L. H. D. S. & de Lazaro, S. R. Influence of the oxygen vacancy and Ag-doping on the magnetic and electronic properties of the SrFeO3 material. J. Magn. Magn. Mater. 591, 171715 (2024).
Abdel-Khalek, E. K., Alluhayb, A. H., Younis, A. M. & Mohamed, E. A. Study the influence of Ag + nanoparticles on the surface of the Sr1-xAgxFeO3-δ perovskite on optical, magnetic and antibacterial properties. J. Sol-Gel Sci. Technol. 112, 44–58 (2024).
Williams, G. V. M., Hemery, E. K. & McCann, D. Magnetic and transport properties of SrFeOx, Phys. Rev. B 79: 024412 (2009).
Raffi, M. et al. Antibacterial characterization of silver nanoparticles against E. coli ATCC-15224. J. Mater. Sci. Technol. 24 (2), 192–196 (2008).
Hodges, J. P. et al. Evolution of Oxygen-Vacancy ordered crystal structures in the perovskite series SrnFenO3n–1 (n = 2, 4, 8, and ∞), and the relationship to electronic and magnetic properties. J. Solid State Chem. 151, 190–209 (2000).
Abdel-Khalek, E. K., Rayan, D. A., Askar, A. A., Maksoud, M. I. A. A. & El- Bahnasawy, H. H. Synthesis and characterization of SrFeO3–δ nanoparticles as antimicrobial agent. J. Sol-Gel Sci. Technol. 97, 27–38 (2021).
Abd El-Naser, A. et al. Study the influence of oxygen-deficient (δ = 0.135) in SrFeO3–δ nanoparticles perovskite on structural, electrical and magnetic properties. Philos. Mag A. 101, 710–728 (2021).
Ahangari, M. et al. Application of SrFeO3 perovskite as electrode material for supercapacitor and investigation of Co-doping effect on the B-site. Turk. J. Chem. 46, 1723–1732 (2022).
Deganello, F., Liotta, L. F., Leonardi, S. G. & Neri, G. Electrochemical properties of Ce-doped SrFeO3 perovskites-modified electrodes towards hydrogen peroxide oxidation. Electrochim. Acta. 190, 939–947 (2016).
Sazinas, R., Andersen, K. B., Simonsen, S. B., Holtappels, P. & Hansen, K. K. Silver modified cathodes for solid oxide fuel cells. J. Electrochem. Soc. 166 (2), F79–F88 (2019).
Long, X. et al. Ag nanoparticles decorated perovskite La0.85Sr0.15MnO3 as electrode materials for supercapacitors. Mater. Lett. 243, 34–37 (2019).
Durán, N. et al. Silver nanoparticles: A new view on mechanistic aspects on antimicrobial activity, Nanomedicine: Nanotechnology, Biology, and Medicine, 12: 789–799 (2016).
Durán, N. et al. Potential use of silver nanoparticles on pathogenic bacteria, their toxicity and possible mechanisms of action. J. Braz Chem. Soc. 21, 949–959 (2010).
Li, Q. et al. Antimicrobial nanomaterials for water disinfection and microbial control: potential applications and implications. Water Res. 42, 4591–4602 (2008).
Mahajan, P., Sharma, A., Kaur, B., Goyal, N. & Gautam, S. Green synthesized (Ocimum sanctum and Allium sativum) Ag-doped Cobalt ferrite nanoparticles for antibacterial application. Vacuum 161, 389–397 (2019).
Yao, C. et al. A Niobium and tungsten co-doped SrFeO3-δ perovskite as cathode for intermediate temperature solid oxide fuel cells. Ceram. Int. 45, 7351–7358 (2019).
Abd-Elwahed, E. S., El-Waseif, A. A. & Maany, D. A. Biosynthesis and FPLC purification of antibacterial peptide from the biotherapeutic agent Enterococcus faecium. Egypt. Pharm. J. 22 (2), 202–208 (2023).
Jiang, J. et al. Surface enhanced Raman scattering detection of pesticide residues using transparent adhesive tapes and coated silver nanorods. ACS Appl. Mater. Interfaces. 10, 9129–9135 (2018).
Brinks, H. W., Fjellvag, H., Kjekshus, A. & Hauback, B. C. Structure and magnetism of Pr1-xSrxFeO3-d. J. Solid State Chem. 150, 233–249 (2000).
Wei, W. et al. High sensitive and fast formaldehyde gas sensor based on Ag-doped LaFeO3 nanofibers. J. Alloys Compd. 695, 1122–1127 (2017).
Liu, P. et al. A high-performance electrode for supercapacitors: silver nanoparticles grown on a porous perovskite-type material La0.7Sr0.3CoO3–δ substrate. Chem. Eng. J. 328, 1–10 (2017).
Berry, F. J., Ren, X., Heap, R., Slater, P. & Thomas, M. F. Fluorination of perovskite-related SrFeO3- δ. Solid State Commun. 134, 621–624 (2005).
Ali, S. E., Wassel, A. R. & El-Mahalawy, A. M. Novel BixLa1-xMnyCo1-yO3 nanocrystalline perovskite based MIS Schottky UV photodetector device. Mater. Res. Bull. 161, 112154 (2023).
Abdel-Latif, I. A. & Zaki, H. M. Study of structure, magnetic and electrical properties of CoFe2-xCrxO4 nanocomposites synthesized using sol-gel method. Mater. Chem. Phys. 275, 125256 (2022).
Abdel-Khalek, E. K., Mohamed, E. A. & Ismail, Y. A. M. Study the role of oxygen vacancies and Mn oxidation States in nonstoichiometric CaMnO3–δ perovskite nanoparticles. J. Sol-Gel Sci. Technol. 113, 461–472 (2025).
Srilakshmi, C., Saraf, R. & Shivakumara, C. Effective degradation of aqueous nitrobenzene using the SrFeO3–δ photocatalyst under UV illumination and its kinetics and mechanistic studies. Ind. Eng. Chem. Res. 54 (32), 7800–7810 (2015).
Augustin, C. O., Berchmans, L. J. & Selvan, R. K. Structural, electrical and electrochemical properties of co-precipitated SrFeO. Mater. Lett. 58, 1260–1266 (2004).
Chen, M. et al. Excellent toluene gas sensing properties of molecular imprinted Ag-LaFeO3 nanostructures synthesized by microwave-assisted process. Mater. Res. Bull. 111, 320–328 (2019).
Abdel-Khalek, E. K., Mohamed, E. A., Rayan, D. A. & Mohamed, S. G. The enhancement of supercapacitors performances of LaMnO3±δ perovskite by Ag-doping. Phys. B. 615, 413065 (2021).
Yu, J. et al. Ag-Modified porous Perovskite-Type LaFeO3 for efficient ethanol detection. Nanomaterials 12, 1768 (2022).
Gao, X., Shang, Y., Liu, L., Nie, W. & Fu, F. )AgCl/Ag/LaFeO3 heterojunction with a prolonged charge lifetime and enhanced visible light catalytic property. J. Phys. Chem. Solids. 127, 186–193 (2019).
Ghaffari, M., Huang, H., Tan, O. K. & Shannon, M. Band gap measurement of SrFeO3–δ by ultraviolet photoelectron spectroscopy and photovoltage method. Cryst. Eng. Comm. 14, 7487–7492 (2012).
Jaiswal, S. K., Kashyap, V. K. & Kumar, J. Effect of magnesium on the XPS and Raman spectra of (Ba0.5Sr0.5)(Al0.2–xMgxFe0.8)O3–ξ (x ≤ 0.2). J. Asian Ceram. Soc. 9, 163–172 (2021).
Chen, M. et al. Ag-LaFeO3 nanoparticles using molecular imprinting technique for selective detection of xylene. Mater. Res. Bull. 107, 271–279 (2018).
Abdel-Khalek, E. K. & Mohamed, H. M. Synthesis, structural and magnetic properties of La1 – xCaxFeO3 prepared by the co-precipitation method. Hyperfine Interact. 222, S57 (2013).
Yousif, A. A. et al. Study on Mӧssbauer and magnetic properties of Strontium - Neodymium ferrimanganites Perovskite-Like structure. AIP Conf. Proc. 1370, 103–107 (2011).
Sh, S. et al. Mössbauer investigations of magnetic system stratification in europium and thulium ferromanganites. Bull. Russian Acad. Sciences: Phys. 74, 343–346 (2010).
Al-Yahmadi, I. Z., Klencsar, Z. & Gismelseed, A. M. Ma’Mari, structural, magnetic and Mössbauer studies of Nd 0.6Sr0.4FexMn1-xO3 perovskites materials. Chem. Phys. 267, 124619 (2021).
Sendilkumar, A. et al. Structural and Mössbauer investigation of nanocrystalline SrFe1 – xTixO3– δ. J. Am. Ceram. Soc. 96, 2973–2978 (2013). [9].
Sh, S., Bashkirov, V. V., Parfenov, I. A., Abdel-Latif, L. D. & Zaripova Mössbauer effect and electrical properties studies of SmFexMn1 – xO3 (x = 0.7, 0.8 and 0.9). J. Alloys Compd. 387, 70–73 (2005).
Schott, S. et al. Superlattice ordering in SrFeO3–δ: Electron microscopy and diffraction study. phys. Stat. Sol (a). 202, 2330–2335 (2005).
Banks, E. & Mizushima, M. Mössbauer study of perovskites of composition SrFe1 – xCrx O3 – y. J. Appl. Phys. 40, 1408 (1969).
Manimuthu, P. & Venkateswaran, C. Evidence of ferroelectricity in SrFeO3–δ. J. Phys. D Appl. Phys. 45, 01530 (2012).
Abdel-Khalek, E. K., Askar, A. A., Motawea, M. A., Aboelnasr, M. A. & El-Bahnasawy, H. H. Study of the influence of synthesis method in BaFeO3–δ perovskite on structural, optical, magnetic and antibacterial properties. Phys. B. 628, 413573 (2022).
Widatallah, H. M. et al. The formation of nanocrystalline SrFeO3 – d using mechano-synthesis and subsequent sintering: structuraland Mössbauer studies. J. Nanosci. Nanotechnol. 9, 2510–2517 (2009).
Tahir, W. et al. Impact of silver substitution on the structural, magnetic, optical, and antibacterial properties of Cobalt ferrite. Sci. Rep. 13, 15730 (2023).
Bhame, S. D., Joly, V. L. J. & Joy, P. A. Effect of disorder on the magnetic properties of LaMn0.5Fe0.5O3. Phys. Rev. B. 72, 054426 (2005).
Abdel-Khalek, E. K., Ibrahim, I., Salama, T. M., Elseman, A. M. & Mohamed, M. M. Structural, optical, dielectric and magnetic properties of Bi1 – xLaxFeO3 nanoparticless. J. Magn. Magn. Mater. 465, 309–315 (2018).
Kumara, A. S. & Srinath, S. Exchange bias effect in Ti doped nanocrystalline SrFeO3–δ. AIP Adv. 4, 087144 (2014).
El-Bassuony, A. A. H., Gamal, W. M. & Abdelsalam, H. K. Fascinating study of adding nanocomposite Cobalt nano ferrite to silver nanoparticles accompanied magnetite impurity. J. Mater. Sci: Mater. Electron. 33, 16219–16235 (2022).
Sivakumar, N., Nagaraju, P., Alsalme, A., Alghamdi, A. & Jayavel, R. Enhanced electrochemical performance of lanthanum ferrite decorated reduced graphene oxide nanocomposite electrodes prepared by in situ microwave irradiation for energy storage applications. Int. J. Energy Res. 45, 5272–5282 (2021).
Mostafa, R. E., Mahmoud, S. S., Tantawy, N. S. & Mohamed, S. G. Carbon and Nitrogen-Co-Doped Se/NiSe2/CoSe2 nanocomposite as superior performance electrode material in hybrid supercapacitors. Chem. Nano Mat. 10 (6), e202300610 (2024).
Acknowledgements
The authors thank Advanced Lab for Energy Storage applications (ALESA), supported by Science, Technology & Innovation Funding Authority (STDF), for doing TEM, HR-TEM, SAED, and EDS elemental mapping measurements. The authors also thank Professor H. H. El-Bahnasawy for helping in the Mössbauer measurement.
Funding
Open access funding provided by The Science, Technology & Innovation Funding Authority (STDF) in cooperation with The Egyptian Knowledge Bank (EKB).
Author information
Authors and Affiliations
Contributions
E. K. Abdel-Khalek: Conceptualization, Investigation, Methodology, Formal analysis, Software, Writing-original draft. Mamduh J. Aljaafreh: Investigation, Software, Methodology, Writing-original draft. Ahmad Saleh: Investigation, Methodology, Writing-original draft. M. M. Osman: Investigation, Methodology, Writing-original draft.
Corresponding author
Ethics declarations
Ethics approval and consent to participate
This article does not contain any studies with human participants or animals performed by any of the authors. I, E. K. Abdel-Khalek, on behalf of all authors, hereby declare that we participated in this manuscript.
Consent for publication
All authors of this paper consent for publishing manuscript, tables, and figures in this journal.
Competing interests
The authors declare no competing interests.
Additional information
Publisher’s note
Springer Nature remains neutral with regard to jurisdictional claims in published maps and institutional affiliations.
Rights and permissions
Open Access This article is licensed under a Creative Commons Attribution 4.0 International License, which permits use, sharing, adaptation, distribution and reproduction in any medium or format, as long as you give appropriate credit to the original author(s) and the source, provide a link to the Creative Commons licence, and indicate if changes were made. The images or other third party material in this article are included in the article’s Creative Commons licence, unless indicated otherwise in a credit line to the material. If material is not included in the article’s Creative Commons licence and your intended use is not permitted by statutory regulation or exceeds the permitted use, you will need to obtain permission directly from the copyright holder. To view a copy of this licence, visit http://creativecommons.org/licenses/by/4.0/.
About this article
Cite this article
Abdel-Khalek, E.K., Aljaafreh, M.J., Saleh, A. et al. Mössbauer, optical, magnetic, electrochemical and antibacterial studies of the Ag/Sr0.85Ag0.15FeO3−δ composite. Sci Rep 15, 23736 (2025). https://doi.org/10.1038/s41598-025-07635-w
Received:
Accepted:
Published:
Version of record:
DOI: https://doi.org/10.1038/s41598-025-07635-w